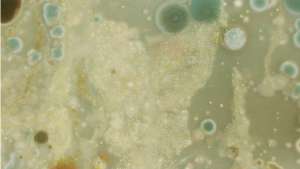

From the Series
First Published in
The Gaia Corporation imagines the world in 2023. It explores the social, political and economic implications of emerging synthetic biology. J Paul Neeley has designed a future business that sets the platform for people to engage with issues surrounding this development, for instance, through collaboration with Nike. The Gaia Corporation’s mission is to act as stewards of the Earth’s intellectual property, to promote and protect biodiversity, and to manage synthetic biological risk. Through both invention and the evolutionary process over hundreds of millions of years, the Earth has created a diverse catalogue of genetic material that can be employed for countless purposes. The Gaia Corporation administers this catalogue and protects it against commercial exploit.
CV: J Paul Neeley is currently completing his Design Interactions Masters at the Royal College of Art. His work explores the human implications and future complexities of emerging technologies through design.
Read "To form or multiply", an investigation into what design can contribute to synthetic biology, written by Alexandra Daisy Ginsberg.